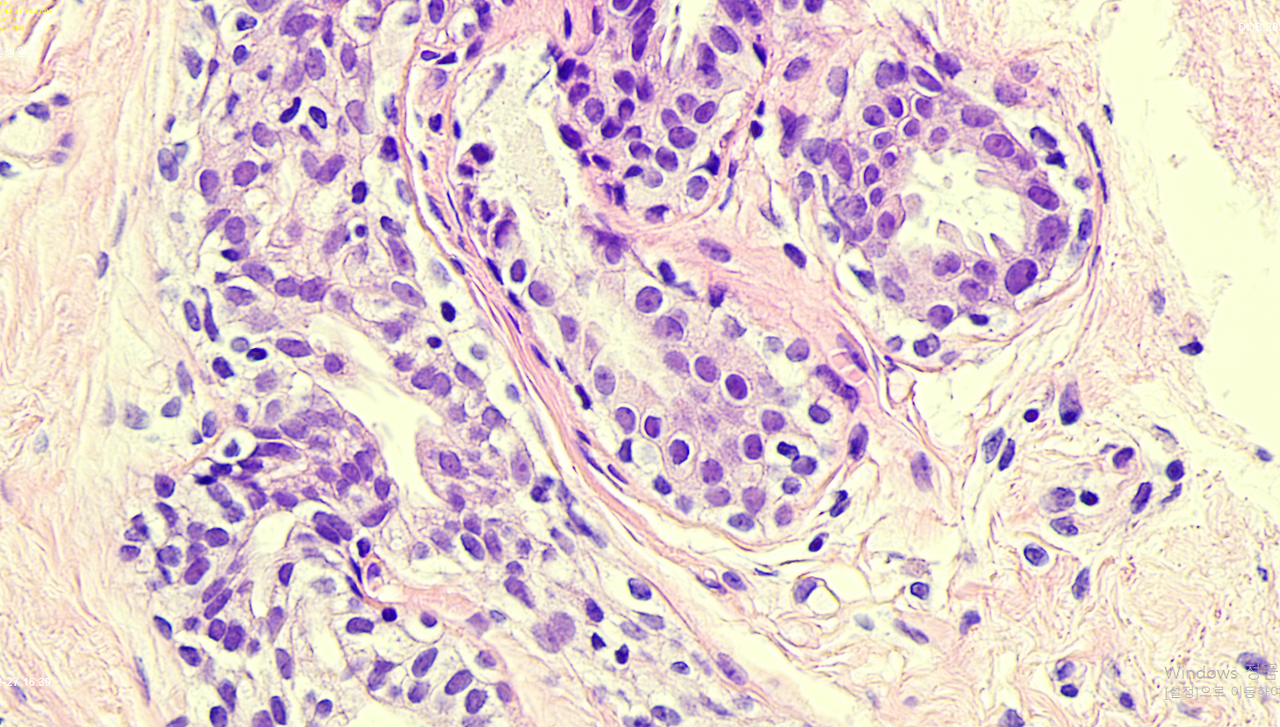

내 암 조직 슬라이드를 고양이 차트에 저장했다
신이 날 보호한다고 생각이 드는 건, 드디어 미쳐서인가.
건강 검진 병원에서 유방암 소견을 알린 전화.
이번 건은 왕 T인 나에게도 살짝 흔들림이 있던 전화이긴 했다.
전혀 예상치 않고 나는 동물병원에서 약을 열심히 지으며 일을 하고 있었기 때문에
"아, 네 알겠습니다." 하고 끊었다.
나의 검사 스케줄로 동물병원 진료 예약들을 옮겨야 하기에, 담담하게 동료들에게 말을 했다.
"쌤, 나 유방암일지도 모르나 봐~"
그러면 쌤들은 흔들리는 눈을 감추고
'괜찮아, 요즘 많아. 다들 잘 살더라고. 괜찮아.'
나 아는 누구 엄마도 유방암이었다더라고, 괜찮아.
괜찮아.
괜찮아.
괜찮아.
괜. 찮. 아.
너무 눈에 보이게 불안해하면서 괜찮다고 해준다.
나는 정말 실감 나지 않아서 걱정도 안 하고, 아무 느낌도 없이, 밥상 앞에 가만히 앉아있는데
누구 엄마도 그랬대 괜찮아, 누구 엄마는 이렇더라고 괜찮아~ 계속 언니에게서도 톡이 온다.
이 정도면 안 괜찮다는 의미 같다... 아... 걱정해야 하는 거 같기도 하다.
민간 병원에서 외부로 조직 검사를 의뢰한 곳에서는 양성과 악성 사이의 경계로 판독을 줬다. 결국 수술적 제거 후 병리 검사로 확정 지으라는 토스의 메시지 같았다.
대학 병원에서는 재판독이 들어가기 때문에 조직 슬라이드와 조직 블럭을 받아왔다.
동물병원에서 일하면 좋은 점은 임신 중일 때는 진료 보다가도 뱃속의 아이가 걱정될 때 짬짬이 초음파로 아이의 심장을 수시로 확인할 수 있고,
임상병리 현미경으로 언제든 나의 암세포도 볼 수 있고.
대학 병원에 제출 전에 동물 병원 현미경으로 조직 슬라이드를 보고 사진을 찍고, 우리 고양이 차트에 내 조직 사진을 저장해 두고 열심히 구글링과 챗GPT로 기준들을 체크했다.

흐음.. 아무리 봐도 찜찜하다. 왜 이렇게 유관 내에 세포들이 빡빡하게 보이지... 기준이 2mm라고...?
대학 병원에서 조직 블럭을 더 슬라이드 쳐보면 확실해지려나.
재판독 기간은 시간이 더디게 갔다.
결국 대학 병원에서는 암으로 진단이 나왔다.
사실, 나의 경우는 말은 '암'이지만 '다행히도 운 좋게' 초기에 발견된 거고 병변이 유관 부분이어서 양성이든, 악성이든 침윤이나 전이가 없다면 치료 방법은 비슷했다.
부분 절제 혹은 전 절제. 플러스마이너스 방사선 치료. (항암까지는 아닐 거야.)
그래서 그런지 더 담담했다. 난 나이롱환자다 하면서.
나의 쏠메(소울메이트) 테크샘은
"쌤은 진짜 대단한 거 같아. 혼자 있을 때도 안 울어? 난 이렇게 못할 거 같아.
그래도 암이잖아. 일도 이렇게 다하고. 여자한테 있어서 가슴 절제나 자궁 적출은 정신적으로 충격이 크게 작용한대. "
라고 말한다.
"어, 눈물이 안 나. 사실 난 너무 힘들었어가지고, 이렇게라도 쉬라는 거 같기도 하고. 내가 뭐 할 수 있는 것도 없고.
내가 한 번쯤 암에 걸려야 한다면, 내가 받을 수 있는 베스트 결과라고 생각해. 침윤도 안 됐고. 아직 병리 검사 전이지만.
그리고 내가 죽을병에 걸렸어도 이제 여한이 없다 생각도 들어. 이렇게 죽어도 그냥 죽겠네 싶어."
"쌤 그거 우울증인 거 같아. "
"그런가, 그럴 수도 있어. 남들은 암이라고 얘기만 들어도 막 운다던데. 그런 게 없네."
난 아직은 너무 해맑게 얘기하는데...
폴댄스 강사님은 잠시 쉬어야 한다고 알려드린 날, 날 끌어안고 엉엉 우시고,
동물 병원 테크샘도 '왜 샘한테 왜에 왜에'하면서 눈물을 훔치고,
보호자분에게 스케줄 양해 차 말씀드리면 눈물로 들어야 할 소식인데 너무 유쾌하게 말씀하신다며 주변 산증인들에게 전화를 돌려 치료 과정이 어떻다더라 발 벗고 나서서 알려주신다.
며칠 전 집에서 반려동물이 무지개다리 건넜다며 마지막 인사를 건네러 오신 보호자분은 내 스크럽복 위에 가디건 옷깃을 다듬어 주시며 "선생님, 치료 잘 받고 와요, 잘 될 거야."라며 눈물이 고이셔서 나는 보호자분에게 위로를 전할 기회를 놓쳤다.
난 왕 T여서인지, 아니면 아직 실감을 못해서인지, 내 감정을 표현하지 못하는 우울증인 건지 잘 모르겠다.
조금 더 시간이 지나면 내 감정을 확실히 알려나?
다른 많은 중증 환자들 속에서 난 혼란스럽다.
많이 아픈 사람들이 저렇게 많은데, 내가 힘들어할 자격이 있나 싶다가도
다 자기의 문제가 제일 큰 거니까 한 번쯤 나도 이기적으로 생각해도 되겠지.. 했다가.
지금은 가호 아래, 잠시 쉼이라 느낀다.
오히려 신이 날 보호한다고 생각이 드는 건, 이제 진짜 미쳐서인가.